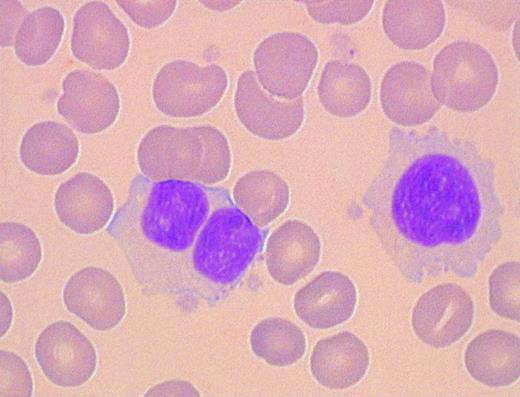
Fig. 2. Morphology of peripheral blood mononuclear cells in persistent PPBL: rare binucleated lymphoid cells coexist with atypical lymphoid cells.

To the Editor:
Hairy B-cell lymphoproliferative disorder (HBLD) was recently identified as a distinct entity: Machii et al1 described four adult patients with the presence of chronic, moderate, and polyclonal lymphocytosis. A few binucleated lymphocytes and atypical lymphoid cells with long microvilli and prominent membranous ruffles on their surfaces were detected on peripheral blood smears. The B cells expressed the CD19, CD11c, and CD22 antigens and were not stained by the anti-CD5, anti-CD24, or anti-CD25 anibodies. Furtheremore, Southern blot analysis and polymerase chain reaction (PCR) amplification of the CDR3 region failed to show a clonal rearrangement of immunoglobulin heavy chain genes.
In adults, persistent lymphocytosis is usually related to B-chronic lymphoproliferative disorders, chronic lymphocytic leukemia (CLL), prolymphocytic leukemia (PLL), splenic lymphoma with villous lymphocytes (SLVL), hairy cell leukemia (HCL) or its variant form (HCL-V), and the leukemic phase of follicular lymphoma. These disorders are characterized by a progressive expansion of a clone of neoplastic B lymphocytes, and all cells in the clone contain the same unique Ig gene rearrangement.
In contrast, a polyclonal lymphocytosis is observed in hyposplenic state, nodular lymphocyte predominance Hodgkin's disease, rheumatoid arthritis, persistent polyclonal B lymphocytosis (PPBL),2,3 and more recently in HCL Japanese variant. We studied 19 patients (17 women and 2 men), median age 40 years (range, 33 to 50) with PPBL. Six of the 19 patients have been previously reported.3 Three patients presented splenomegaly and no patient had hepatomegaly or adenopathy. All patients presented an absolute lymphocytosis: the majority of lymphocytes were large with abondant faintly, basophilic cytoplasm (Fig 1, see page 2111) and in all patients a characteristic nuclei demonstrating a rounded or more commonly irregular form, with variable (2% to 9%) numbers of binucleated cells (Fig 2, see page 2111). Despite chronic lymphocytosis and morphology of the lymphoid cells similar to that of the lymphoid B cells of HBLD, a close relationship was excluded between both entities. Environmental (tobacco) factors have been implicated in the etiology of PPBL but we observed one female patient who never smoked. In a recent review based on 38 patients with PPBL, 24 of 27 patients with PPBL were HLA-DR7-positive4: 3 patients expressed DR4 in our series. The CD11c antigen was expressed in 3 of 13 cases and 5 of 17 patients had a high serum level of IgG. Cytogenetic analysis was performed in 18 of 19 patients: 16 patients showed the presence of an extra chromosome 3 long arm i(3q)5 (Fig 3). Premature chromosome condensation (PCC) was also observed in 15 patients. The morphology of the PCC indicated condensation of G1 and G2 cells, exhibiting single and double chromatids, respectively. Thirteen patients presented both abnormalities. In contrast, 100 metaphases each from 5 cases of B-CLL and 5 healthy donors failed to show either PCC or i(3q). The i(3q) was observed almost exclusively following culture in TPA-LPS, which encourages B-lymphoid proliferation when compared with culture in PHA-IL2, stimulating predominantly T-cell proliferation. Likewise, the PCC was also more common in the presence of TPA-LPS. Because both abnormalities are rarely present in other benign or malignant proliferations, we also suggested a strong correlation between PPBL and i(3q) and/or PCC. Fluorescence in situ hybridization (FISH) with a chromosome 3 α-satellite specific probe (Oncor) confirmed the presence of an i(3q) in 16 of 18 cases (Fig 4). In 2 patients conventional cytogenetics and FISH failed to detect an i(3q). PCR amplification of the IgH V-D-J junctional sequences using both FR1 and FR3 primers confirmed the polyclonal nature of the lymphocytosis in 15 of 15 patients.
Morphology of peripheral blood mononuclear cells in persistent PPBL: the majority of lymphocytes were large with abondant faintly, basophilic cytoplasm (May-Grünwald-Giemsa).
Morphology of peripheral blood mononuclear cells in persistent PPBL: the majority of lymphocytes were large with abondant faintly, basophilic cytoplasm (May-Grünwald-Giemsa).
Morphology of peripheral blood mononuclear cells in persistent PPBL: rare binucleated lymphoid cells coexist with atypical lymphoid cells.
Morphology of peripheral blood mononuclear cells in persistent PPBL: rare binucleated lymphoid cells coexist with atypical lymphoid cells.
To exclude PPBL diagnosis, it would be useful to be aware of chromosomes analysis in patients with HBLD. The benign clinical course of PPBL (median follow-up, 11 years) and the lack of biological evolution in the majority of cases suggest that recognition of these disorders is important so that aggressive therapy in PPBL and HBLD has to be avoided. Whether this syndrome represents a premalignant or benign disease remains unclear, although prolonged follow-up suggests that, if malignant progression occurs, it demonstrates a long latency. Despite of cytogenetic abnormalities, chemotherapy is unnecessary in most cases.
Response
Troussard et al questioned the difference between persistent polyclonal B lymphocytosis (PPBL)1-1 and hairy B-cell lymphoproliferative disorder (HBLD).1-2 Both PPBL and HBLD have persistent expansion of polyclonal B cells, but the clinical and laboratory features are significantly different. We found features resembling hairy cell leukemia (HCL)-Japanese variant in four cases having persistent expansion of B cells.1-2 In addition to these patients, three patients were newly diagnosed as HBLD. The seven patients comprised five females and two males. Six of seven patients had splenomegaly and showed anemia and/or thrombopenia. Few binucleated lymphocytes (<0.5%) were detected in the peripheral blood lymphocytes from these patients. All five female patients were nonsmokers. Although one of two males was a smoker, many Japanese males have this habit. HLA typing performed in six patients showed that none had DR7 phenotype.
On the other hand, the surface morphology of most of the circulating lymphocytes from all seven patients showed long microvilli and prominent ruffles, which could be easily observed under by phase-contrast and scanning electron microscopy. The histopathologic features of bone marrow specimens obtained from two patients were also similar to those described for HCL.1-2 In addition, spleen tissue obtained from one patient showed diffuse infiltration of lymphoid cells with round nuclei and abundant clear cytoplasm in the red pulp (unpublished observation, April 1997). Those features resembling HCL were not observed in the peripheral blood lymphocytes, bone marrow, and spleen in PPBL.1-1,1-3 The lymphocytes from all seven cases expressed surface IgG and were CD5−, CD11c+, CD24−, CD25−, which is identical to the phenotype of the leukemic cells in HCL-Japanese variant.1-4 In addition, all of these patients had high levels of serum IgG with variable levels of serum IgA and IgM.
The majority of patients with PPBL are smokers and are HLA-DR7-positive.1-1,1-3,1-5 A high level of serum IgM is invariably seen in PPBL, and serum IgA and IgG levels are frequently low or normal. On the basis of these immunological findings, Perreault et al1-3 suggested a defect in class switching from IgM to IgG and IgA in PPBL, but it is not the case in HBLD. Although Troussard et al described that some features of HBLD were seen in a small portion of PPBL, combination of the clinical and laboratory findings is important for differentiation between PPBL and HBLD. If PPBL and HBLD are the same entity, we would expect to find patients with such feature as seen in the majority of those with PPBL. Polyclonal B-cell expansion was detected only in these 7 cases among about 200 cases with B-cell lymphocytosis referred to our laboratory.
The benign clinical course in PPBL was well documented.1-1,1-3,1-5 Splenomegaly and cytopenia appear to be slight in PPBL, if they occur at all, and no patients have been reported who received specific therapy for the disease, although chemotherapy was performed in a few patients due to misdiagnosis of lymphoid malignancies.1-3 On the other hand, three of seven patients with HBLD had a huge spleen expanding below the umbilical line accompanied by anemia and/or thrombopenia, and complained of anorexia and abdominal discomfort. Large spleen size in these patients suggests a progressive clinical course, and in fact, one patient showed gradual exacerbation of splenomegaly and cytopenia.1-2 Splenectomy was performed in another patient, resulting in relief of the complaints and cytopenia. These findings suggest that a proportion of patients with HBLD have a slowly progressive course resembling HCL, which may necessitate a specific therapy, and that splenectomy is also effective in HBLD as is in the case of HCL.
Troussard et al described an interesting finding that the majority of patients with PPBL have isochromosome i(3q). They investigated more than 100 metaphases in each patient and detected i(3q) in a small proportion of the lymphocytes.1-6 As they pointed out, cytogenetic studies are important for characterization of HBLD. We performed chromosome analyses in some of our patients, but we could examine only lesser numbers of metaphases and no karyotypic abnormalities were detected. Most of the lymphocytes stimulated with TPA underwent morphological changes into a fibroblast-like elongated shape.1-2 These morphological changes and a low mitotic activity induced by TPA were characteristically seen in the HCL cells.1-7 Therefore, we started further chromosome analyses of HBLD upon stimulation via the CD40 antigen; the system was found to be useful for the cytogenetic study in HCL.1-8 The data reported by Troussard strongly suggest that i(3q) is correlated with PPBL, but the abnormality is detected in only a small portion of the expanded lymphocytes, and its implications for the pathogenesis of PPBL and in the differentiation between PPBL and HBLD remain elusive.
Many interesting findings have been described for PPBL, but the etiology is still unknown. Although PPBL and HBLD are rare, studies of these disorders would be useful for understanding B-cell differentiation and proliferation in physiological and pathological conditions.

This feature is available to Subscribers Only
Sign In or Create an Account Close Modal